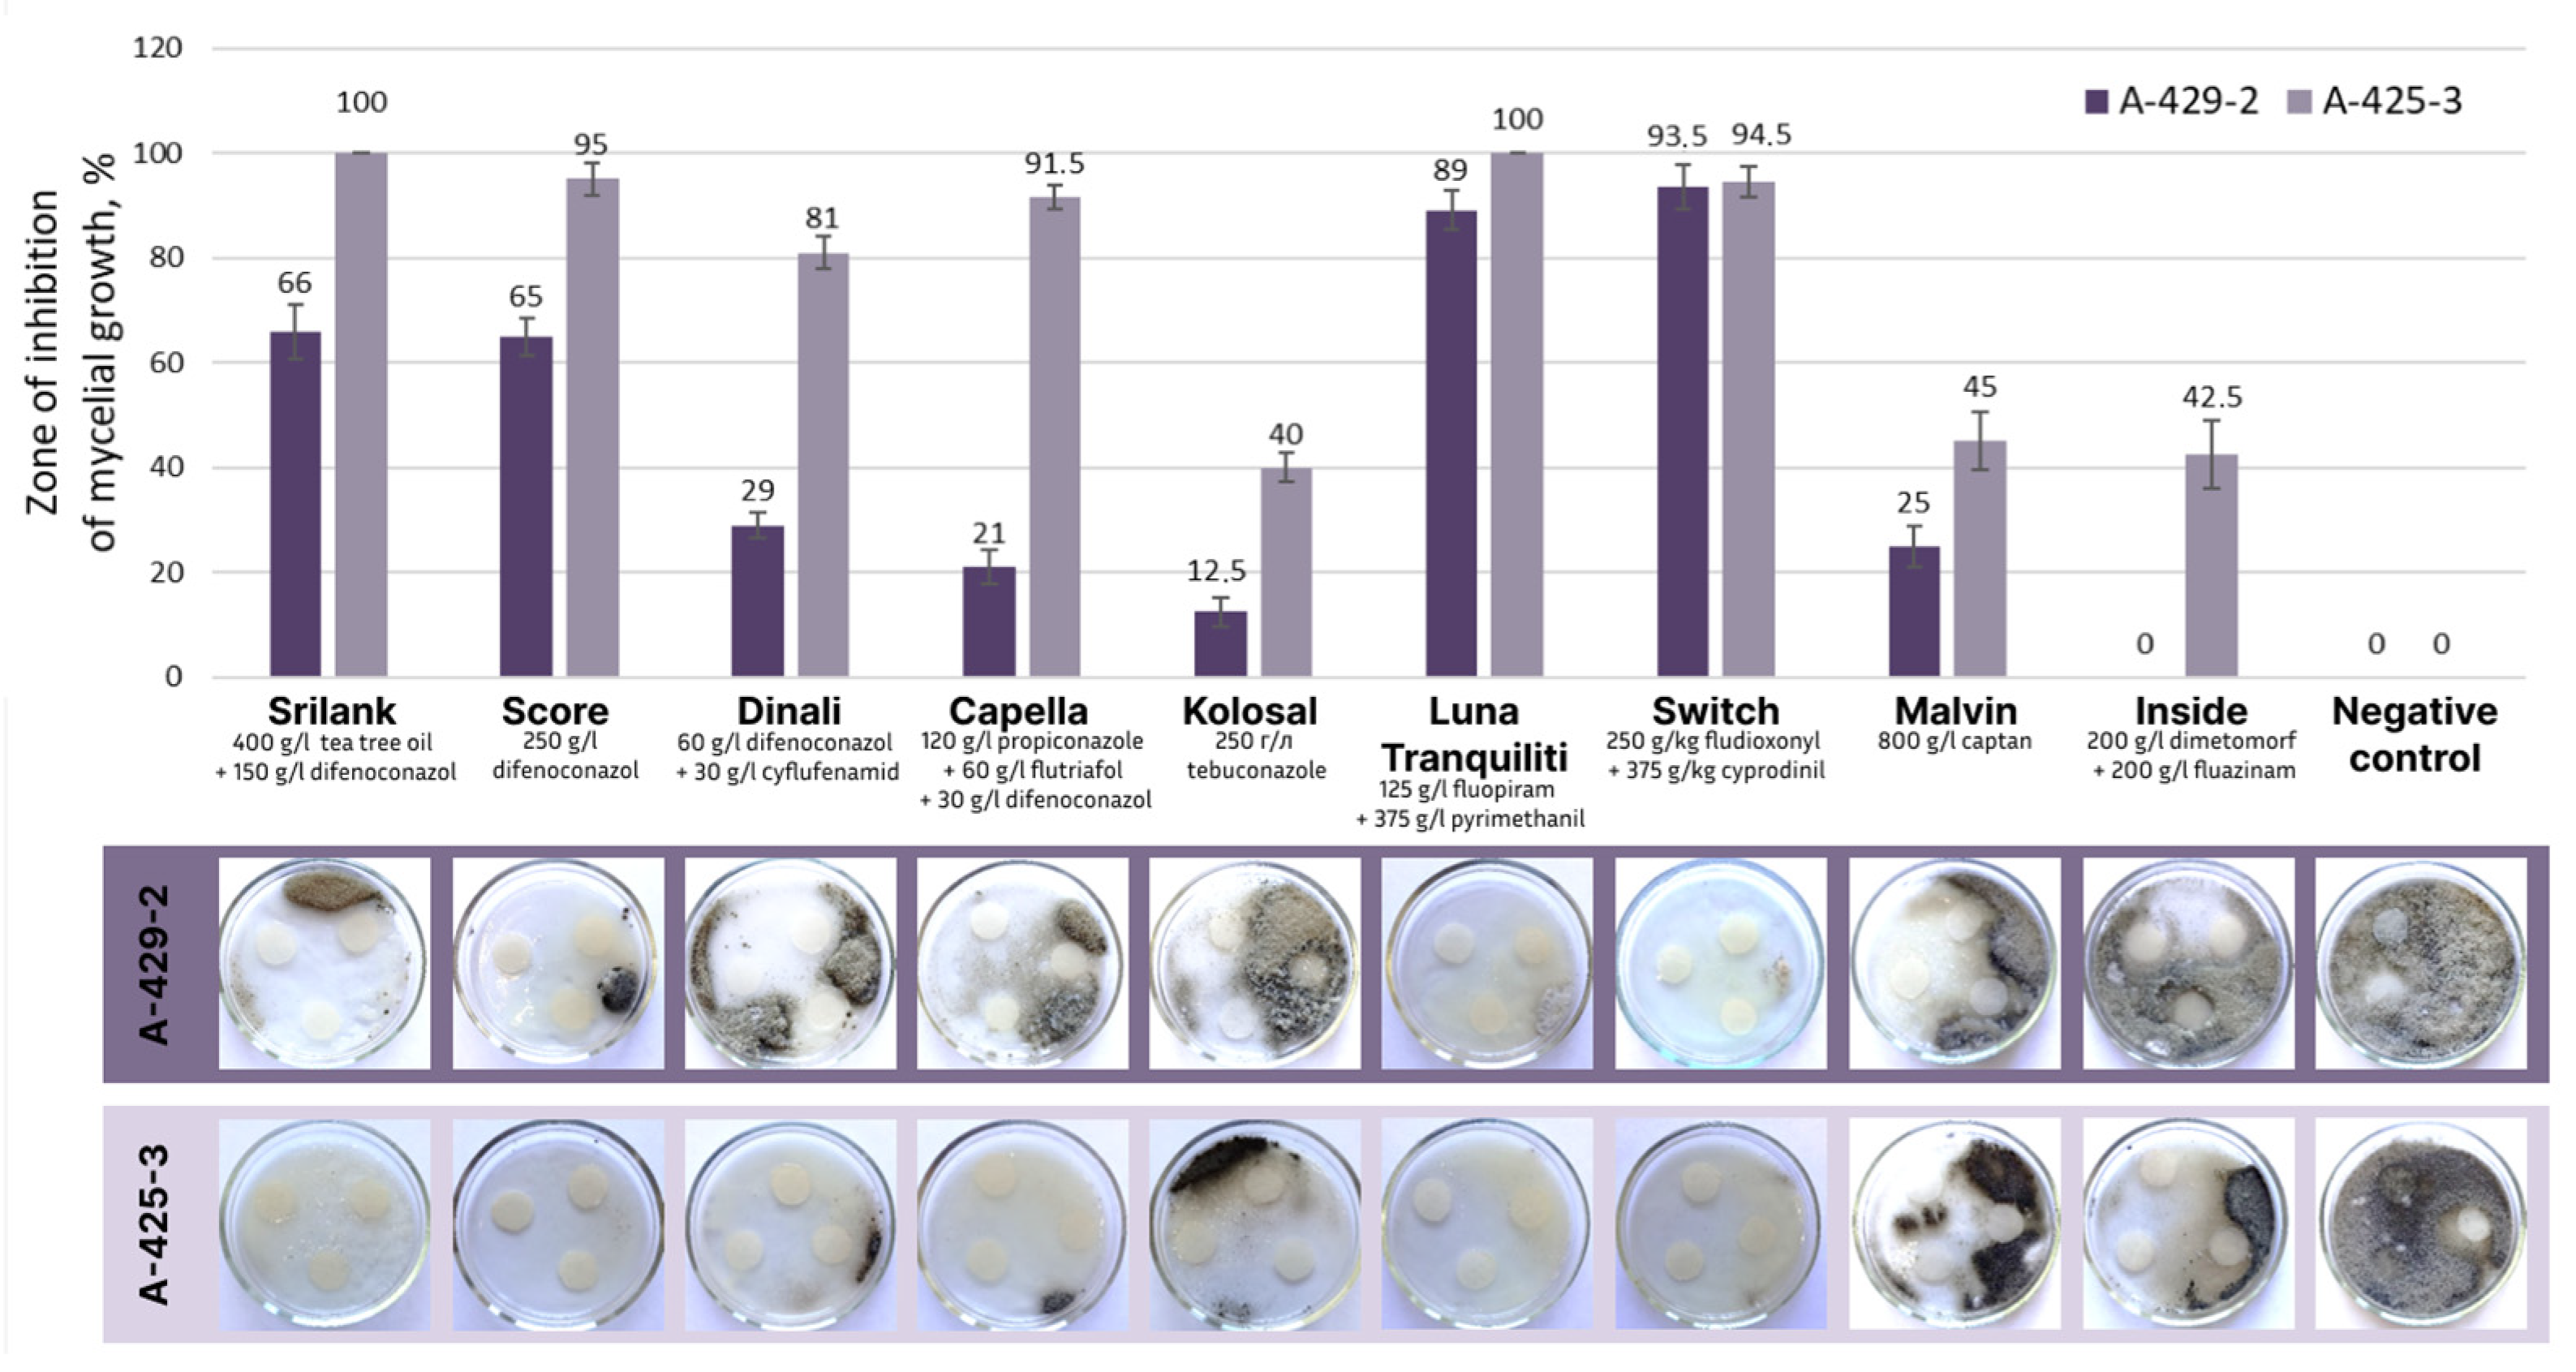
Plants 13 03335 g007

Leaf Spot Caused by Alternaria spp. Is a New Disease of Grapevine
Abstract
1. Introduction
2. Results
2.1. Symptoms and Samples Collection
2.2. Morphological Characterization of Isolates
2.3. Pathogenicity Test
2.4. Molecular Genetic Analysis
2.5. Screening of Fungicides and Antagonists Against Alternaria sp.
3. Discussion
4. Materials and Methods
4.1. Field Survey and Morphological Characterization of Alternaria spp.
4.2. Pathogenicity Test
4.3. DNA Extraction, Sequencing, and Phylogenetic Analysis
4.4. Screening of Alternaria sp. Sensitivity to Fungicides and Assessment of Antagonistic Activity of Trichoderma sp.
Supplementary Materials
Author Contributions
Funding
Data Availability Statement
Acknowledgments
Conflicts of Interest
References
- International Organisation of Vine and Wine. Country Statistics. Available online: https://www.oiv.int/what-we-do/country-report?oiv= (accessed on 2 November 2024).
- Armijo, G.; Schlechter, R.; Agurto, M.; Muñoz, D.; Nuñez, C.; Arce-Johnson, P. Grapevine Pathogenic Microorganisms: Understanding Infection Strategies and Host Response Scenarios. Front. Plant Sci. 2016, 7, 382. [Google Scholar] [CrossRef] [PubMed]
- Pirrello, C.; Mizzotti, C.; Tomazetti, T.C.; Colombo, M.; Bettinelli, P.; Prodorutti, D.; Peressotti, E.; Zulini, L.; Stefanini, M.; Angeli, G.; et al. Emergent Ascomycetes in Viticulture: An Interdisciplinary Overview. Front. Plant Sci. 2019, 10, 1394. [Google Scholar] [CrossRef] [PubMed]
- Anderson, P.K.; Cunningham, A.A.; Patel, N.G.; Morales, F.J.; Epstein, P.R.; Daszak, P. Emerging Infectious Diseases of Plants: Pathogen Pollution, Climate Change and Agrotechnology Drivers. Trends Ecol. Evol. 2004, 19, 535–544. [Google Scholar] [CrossRef] [PubMed]
- Giraud, T.; Gladieux, P.; Gavrilets, S. Linking the Emergence of Fungal Plant Diseases with Ecological Speciation. Trends Ecol. Evol. 2010, 25, 387–395. [Google Scholar] [CrossRef] [PubMed]
- Yurchenko, E.G.; Savchuk, N.V.; Porotikova, E.V.; Vinogradova, S.V. First Report of Grapevine (Vitis sp.) Cluster Blight Caused by Fusarium proliferatum in Russia. Plant Dis. 2020, 104, 991. [Google Scholar] [CrossRef]
- Li, P.; Tedersoo, L.; Crowther, T.W.; Wang, B.; Shi, Y.; Kuang, L.; Li, T.; Wu, M.; Liu, M.; Luan, L.; et al. Global Diversity and Biogeography of Potential Phytopathogenic Fungi in a Changing World. Nat. Commun. 2023, 14, 6482. [Google Scholar] [CrossRef]
- Gannibal, P.B. Alternaria cucumerinacausing Causing Leaf Spot of Pumpkin Newly Reported in North Caucasus (Russia). New Dis. Rep. 2011, 23, 36. [Google Scholar] [CrossRef]
- Tao, W.C.; Zhang, W.; Yan, J.Y.; Hyde, K.D.; McKenzie, E.H.C.; Li, X.H.; Wang, Y. A New Alternaria Species from Grapevine in China. Mycol. Prog. 2014, 13, 1119–1125. [Google Scholar] [CrossRef]
- Dang, J.L.; Gleason, M.L.; Li, L.N.; Wang, C.; Niu, C.K.; Zhang, R.; Sun, G.Y. Alternaria malicola sp. nov., a New Pathogen Causing Fruit Spot on Apple in China. Plant Dis. 2018, 102, 1273–1282. [Google Scholar] [CrossRef]
- Liu, H.F.; Liao, J.; Chen, X.Y.; Liu, Q.K.; Yu, Z.H.; Deng, J.X. A Novel Species and a New Record of Alternaria Isolated from Two Solanaceae Plants in China. Mycol. Prog. 2019, 18, 1005–1012. [Google Scholar] [CrossRef]
- Matić, S.; Tabone, G.; Garibaldi, A.; Gullino, M.L. Alternaria Leaf Spot Caused by Alternaria Species: An Emerging Problem on Ornamental Plants in Italy. Plant Dis. 2020, 104, 2275–2287. [Google Scholar] [CrossRef] [PubMed]
- Gannibal, P.B.; Orina, A.S.; Gasich, E.L. A New Section for Alternaria helianthiinficiens Found on Sunflower and New Asteraceous Hosts in Russia. Mycol. Prog. 2022, 21, 34. [Google Scholar] [CrossRef]
- Ivanović, Ž.; Blagojević, J.; Jovanović, G.; Ivanović, B.; Žeželj, D. New Insight in the Occurrence of Early Blight Disease on Potato Reveals High Distribution of Alternaria solani and Alternaria protenta in Serbia. Front. Microbiol. 2022, 13, 856898. [Google Scholar] [CrossRef] [PubMed]
- Li, J.F.; Jiang, H.B.; Jeewon, R.; Hongsanan, S.; Bhat, D.J.; Tang, S.M.; Lumyong, S.; Mortimer, P.E.; Xu, J.C.; Camporesi, E.; et al. Alternaria: Update on Species Limits, Evolution, Multi-Locus Phylogeny, and Classification. Stud. Fungi 2023, 8, 1. [Google Scholar] [CrossRef]
- Lawrence, C.B.; Craven, K.D.; Cramer, R.A.; Kim, K.-H. At Death’s Door Alternaria Pathogenicity Mechanisms. Plant Pathol. J. 2008, 24, 101–111. [Google Scholar] [CrossRef]
- Thomma, B.P.H.J. Alternaria spp.: From General Saprophyte to Specific Parasite. Mol. Plant Pathol. 2003, 4, 225–236. [Google Scholar] [CrossRef]
- Tsuge, T.; Harimoto, Y.; Akimitsu, K.; Ohtani, K.; Kodama, M.; Akagi, Y.; Egusa, M.; Yamamoto, M.; Otani, H. Host-Selective Toxins Produced by the Plant Pathogenic Fungus Alternaria alternata. FEMS Microbiol. Rev. 2013, 37, 44–66. [Google Scholar] [CrossRef]
- Kodama, M. Evolution of Pathogenicity in Alternaria Plant Pathogens. J. Gen. Plant Pathol. 2019, 85, 471–474. [Google Scholar] [CrossRef]
- Singh, G.; Naresh, S.; Prabhu, M.; Meena, D. Alternaria Diseases of Crucifers: Biology, Ecology and Disease Management; Springer: Singapore, 2016. [Google Scholar]
- Simmons, E.G. Alternaria: An Identification Manual; CBS Biodiversity Series; Centraalbureau Voor Schimmelcultures: Utrecht, The Netherlands, 2007; Volume 6, 780p. [Google Scholar]
- Nishimura, S.; Kohmoto, K. Host-Specific Toxins and Chemical Structure from Alternaria Species. Annu. Rev. Phytopathol. 1983, 21, 87–116. [Google Scholar] [CrossRef]
- Kusaba, M.; Tsuge, T. Nuclear Ribosomal DNA Variation and Pathogenic Specialization in Altemaria Fungi Known To Produce Host-Specific Toxins. Appl. Environ. Microbiol. 1994, 60, 3055–3062. [Google Scholar] [CrossRef]
- Runa, F.; Park, M.S.; Pryor, B.M. Ulocladium Systematics Revisited: Phylogeny and Taxonomic Status. Mycol. Prog. 2009, 8, 35–47. [Google Scholar] [CrossRef]
- Pryor, B.M.; Gilbertson, R.L. Molecular Phylogenetic Relationships amongst Alternaria Species and Related Fungi Based upon Analysis of Nuclear ITS and Mt SSU RDNA Sequences. Mycol. Res. 2000, 104, 1312–1321. [Google Scholar] [CrossRef]
- Lawrence, D.P.; Gannibal, P.B.; Peever, T.L.; Pryor, B.M. The Sections of Alternaria: Formalizing Species-Group Concepts. Mycologia 2013, 105, 530–546. [Google Scholar] [CrossRef] [PubMed]
- Woudenberg, J.H.C.; Groenewald, J.Z.; Binder, M.; Crous, P.W. Alternaria Redefined. Stud. Mycol. 2013, 75, 171–212. [Google Scholar] [CrossRef]
- Woudenberg, J.H.C.; Seidl, M.F.; Groenewald, J.Z.; de Vries, M.; Stielow, J.B.; Thomma, B.P.H.J.; Crous, P.W. Alternaria Section Alternaria: Species, Formae Speciales or Pathotypes? Stud. Mycol. 2015, 82, 1–21. [Google Scholar] [CrossRef]
- Morris, P.F.; Connolly, M.S.; St Clair, D.A. Genetic Diversity of Alternaria alternata Isolated from Tomato in California Assessed Using RAPDs. Mycol. Res. 2000, 104, 286–292. [Google Scholar] [CrossRef]
- Bock, C.H.; Thrall, P.H.; Brubaker, C.L.; Burdon, J.J. Detection of Genetic Variation in Alternaria brassicicola Using AFLP Fingerprinting. Mycol. Res. 2002, 106, 428–434. [Google Scholar] [CrossRef]
- Anand, G.; Kapoor, R. Population Structure and Virulence Analysis of Alternaria carthami Isolates of India Using ISSR and SSR Markers. World J. Microbiol. Biotechnol. 2018, 34, 140. [Google Scholar] [CrossRef]
- Singh, R.; Kumar, S.; Kashyap, P.L.; Srivastava, A.K.; Mishra, S.; Sharma, A.K. Identification and Characterization of Microsatellite from Alternaria brassicicola to Assess Cross-Species Transferability and Utility as a Diagnostic Marker. Mol. Biotechnol. 2014, 56, 1049–1059. [Google Scholar] [CrossRef]
- Pavón, M.Á.; González, I.; Rojas, M.; Pegels, N.; Martín, R.; García, T. PCR Detection of Alternaria spp. in Processed Foods, Based on the Internal Transcribed Spacer Genetic Marker. J. Food Prot. 2011, 74, 240–247. [Google Scholar] [CrossRef]
- Soo, M.; Casey, P.; Romanoski, E.; Pryor, B.M. A Re-Examination of the Phylogenetic Relationship between the Causal Agents of Carrot Black Rot, Alternaria radicina and A. carotiincultae. Mycologia 2008, 100, 511–527. [Google Scholar] [CrossRef]
- Lawrence, D.P.; Gannibal, P.B.; Dugan, F.M.; Pryor, B.M. Characterization of Alternaria Isolates from the Infectoria Species-Group and a New Taxon from Arrhenatherum, Pseudoalternaria arrhenatheria sp. nov. Mycol. Prog. 2014, 13, 257–276. [Google Scholar] [CrossRef]
- Zhu, X.Q.; Xiao, C.L. Phylogenetic, Morphological, and Pathogenic Characterization of Alternaria Species Associated with Fruit Rot of Blueberry in California. Phytopathology 2015, 105, 1555–1567. [Google Scholar] [CrossRef] [PubMed]
- Ahmad, T.; Xing, F.; Cao, C.; Liu, Y. Characterization and Toxicological Potential of Alternaria alternata Associated with Post-Harvest Fruit Rot of Prunus avium in China. Front. Microbiol. 2024, 15, 1273076. [Google Scholar] [CrossRef] [PubMed]
- Hong, S.G.; Cramer, R.A.; Lawrence, C.B.; Pryor, B.M. Alt a 1 Allergen Homologs from Alternaria and Related Taxa: Analysis of Phylogenetic Content and Secondary Structure. Fungal Genet. Biol. 2005, 42, 119–129. [Google Scholar] [CrossRef]
- Wang, H.; Liu, H.; Lu, X.; Zhou, Q. First Report of Leaf Spot in Farfugium japonicum Caused by Alternaria alternata in China. Plant Dis. 2021, 105, 2715. [Google Scholar] [CrossRef]
- Peever, T.L.; Carpenter-Boggs, L.; Timmer, L.W.; Carris, L.M.; Bhatia, A. Citrus Black Rot Is Caused by Phylogenetically Distinct Lineages of Alternaria alternata. Phytopathology 2005, 95, 512–518. [Google Scholar] [CrossRef]
- Lyu, Y.Z.; Dong, X.Y.; Sun, H.N.; Li, R.; Li, S.; Hu, L.J.; Huang, L.B. First Report of Alternaria Leaf Spot Caused by Alternaria alternata on Ulmus parvifolia in Jiangsu, China. Plant Dis. 2024, 108, 807. [Google Scholar] [CrossRef]
- Landschoot, S.; Vandecasteele, M.; Carrette, J.; De Baets, B.; Höfte, M.; Audenaert, K.; Haesaert, G. Assessing the Belgian Potato Alternaria Population for Sensitivity to Fungicides with Diverse Modes of Action. Eur. J. Plant Pathol. 2017, 148, 657–672. [Google Scholar] [CrossRef]
- Kgatle, M.G.; Flett, B.; Truter, M.; Aveling, T.A.S. Control of Alternaria Leaf Blight Caused by Alternaria alternata on Sunflower Using Fungicides and Bacillus amyloliquefaciens. Crop Prot. 2020, 132, 105146. [Google Scholar] [CrossRef]
- Zhao, W.; Sun, C.; Wei, L.; Chen, W.; Wang, B.; Li, F.; Wei, M.; Lou, T.; Zhang, P.; Zheng, H.; et al. Detection and Fitness of Dicarboximide-Resistant Isolates of Alternaria alternata from Dendrobium officinale, a Chinese Indigenous Medicinal Herb. Plant Dis. 2020, 105, 2222–2230. [Google Scholar] [CrossRef] [PubMed]
- Wang, H.C.; Zhang, C.Q. Multi-Resistance to Thiophanate-Methyl, Diethofencarb, and Procymidone among Alternaria alternata Populations from Tobacco Plants, and the Management of Tobacco Brown Spot with Azoxystrobin. Phytoparasitica 2018, 46, 677–687. [Google Scholar] [CrossRef]
- Ishii, H.; Bryson, P.K.; Kayamori, M.; Miyamoto, T.; Yamaoka, Y.; Schnabel, G. Cross-Resistance to the New Fungicide Mefentrifluconazole in DMI-Resistant Fungal Pathogens. Pestic. Biochem. Physiol. 2021, 171, 104737. [Google Scholar] [CrossRef] [PubMed]
- Chrapačienė, S.; Rasiukevičiūtė, N.; Valiuškaitė, A. Control of Seed-Borne Fungi by Selected Essential Oils. Horticulturae 2022, 8, 220. [Google Scholar] [CrossRef]
- Kurniawan, O.; Wilson, K.; Mohamed, R.; Avis, T.J. Bacillus and Pseudomonas spp. Provide Antifungal Activity against Gray Mold and Alternaria Rot on Blueberry Fruit. Biol. Control 2018, 126, 136–141. [Google Scholar] [CrossRef]
- Komhorm, A.; Thongmee, S.; Thammakun, T.; Oiuphisittraiwat, T.; Jantasorn, A. In Vivo Testing of Antagonistic Fungi against Alternaria brassicicola Causing Chinese Kale Black Spot Disease. J. Plant Dis. Prot. 2021, 128, 183–189. [Google Scholar] [CrossRef]
- Yurchenko, E.G.; Savchuk, N.V.; Burovinskaya, M.V. New harmful mycopathogens in ampelocenoses of the western caucasus. Sci. Work. Fsbsi Ncfschvw 2020, 28, 153–157. [Google Scholar] [CrossRef]
- Burovinskaya, M.; Maslienko, L.; Yurchenko, E. Micromycetes Antagonistic Potential in Vitro against Alternaria sp., a Pathogenic Strain Associated with Grapes. BIO Web Conf. 2021, 34, 04011. [Google Scholar] [CrossRef]
- Paradiso, G.; Spada, A.; Nerva, L.; Chitarra, W. First Report of Alternaria alternata Complex Causing Leaf Spot on Vitis vinifera in Italy. Plant Dis. 2024, 108, 3196. [Google Scholar] [CrossRef]
- Sturrock, R.N.; Frankel, S.J.; Brown, A.V.; Hennon, P.E.; Kliejunas, J.T.; Lewis, K.J.; Worrall, J.J.; Woods, A.J. Climate Change and Forest Diseases. Plant Pathol. 2011, 60, 133–149. [Google Scholar] [CrossRef]
- Fairchild, K.L.; Miles, T.D.; Wharton, P.S. Assessing Fungicide Resistance in Populations of Alternaria in Idaho Potato Fields. Crop Prot. 2013, 49, 31–39. [Google Scholar] [CrossRef]
- Nuwamanya, A.M.; Mwangi, M.; Runo, S. In-Vitro Sensitivity of Alternaria solani Isolates to Azoxystrobin and Difenoconazole Fungicides in Kenya and detection of Cyt b mutations associated with azoxystrobin resistance. SSRN Electron. J. 2022, 158, 106010. [Google Scholar] [CrossRef]
- Wang, F.; Saito, S.; Michailides, T.J.; Xiao, C.L. Fungicide Resistance in Alternaria alternata from Blueberry in California and Its Impact on Control of Alternaria Rot. Plant Dis. 2022, 106, 1446–1453. [Google Scholar] [CrossRef] [PubMed]
- Abo-Elyousr, K.A.M.; Abdel-Hafez, S.I.I.; Abdel-Rahim, I.R. Isolation of Trichoderma and Evaluation of Their Antagonistic Potential against Alternaria porri. J. Phytopathol. 2014, 162, 567–574. [Google Scholar] [CrossRef]
- Yassin, M.T.; Mostafa, A.A.F.; Al-Askar, A.A. In Vitro Antagonistic Activity of Trichoderma spp. against Fungal Pathogens Causing Black Point Disease of Wheat. J. Taibah Univ. Sci. 2022, 16, 57–65. [Google Scholar] [CrossRef]
- Leyronas, C.; Duffaud, M.; Nicot, P.C. Compared Efficiency of the Isolation Methods for Botrytis cinerea. Mycology 2012, 3, 221–225. [Google Scholar] [CrossRef]
- Trinci, A.P.J. Influence of the Width of the Peripheral Growth Zone on the Radial Growth Rate of Fungal Colonies on Solid Media. Micribiology Soc. 1971, 67, 325–344. [Google Scholar] [CrossRef]
- Bukhalo, A.S. Higher Edible Basidiomycetes in Pure Culture; Sciences Dumka: Kiev, Ukraine, 1988; pp. 44–45. [Google Scholar]
- Dyakov, Y.T.; Sergeev, Y.V. New in the Systematics and Nomenclature of Fungi; All-Russian public organization “Public National Academy of Mycology”: Moscow, Russia, 2003; pp. 1–496. [Google Scholar]
- Poliksenova, V.D.; Khramtsov, A.K.; Piskun, S.G. Methodological Guidelines for Special Practice Classes in the Section “Mycology. Methods of Experimental Study of Microscopic Fungi”; BSU: Minsk, Belarus, 2004. [Google Scholar]
- Satton, D.; Fothergill, M. Determinant of Pathogenic and Conditionally Pathogenic Fungi; Mir: Moscow, Russia, 2001; pp. 1–486. [Google Scholar]
- Blagoveshchenskaya, E.U. Mycological Research: Fundamentals of Laboratory Technology; Lenand: Moscow, Russia, 2017; pp. 1–96. [Google Scholar]
- Al-Sanae, E.A.M.; Shehata, A.I.; Bahkali, A.H.; Yahya, M.A.; Al Hazzani, A.A. Molecular Detection and Characterization of Fusarium sporotrichioides basedon ITS2 rDNA Polymorphism. Polymorph. Hum. J. 2016, 2, 365–376. [Google Scholar]
- White, T.J.; Bruns, T.D.; Lee, S.B.; Taylor, J. Amplification and Direct Sequencing of Fungal Ribosomal RNA Genes for Phylogenetics. In PCR Protocols: A Guide to Methods and Applications; Academic Press: New York, NY, USA, 1990; pp. 315–322. [Google Scholar]
- Berbee, M.L.; Pirseyedi, M.; Hubbard, S. Cochliobolus Phylogenetics and the Origin of Known, Highly Virulent Pathogens, Inferred from ITS and Glyceraldehyde-3-Phosphate Dehydrogenase Gene Sequences. Mycologia 1999, 91, 964–977. [Google Scholar] [CrossRef]
- O’donnell, K.; Cigelnik, E. Two Divergent Intragenomic RDNA ITS2 Types within a Monophyletic Lineage of the Fungus Fusarium Are Nonorthologous. Mol. Phylogenetics Evol. 1997, 7, 103–116. [Google Scholar] [CrossRef]
- Peever, T.L.; Su, G.; Carpenter-Boggs, L.; Timmer, L.W. Molecular Systematics of Citrus-Associated Alternaria Species. Mycologia 2004, 96, 119–134. [Google Scholar] [CrossRef] [PubMed]
- Somma, S.; Amatulli, M.T.; Masiello, M.; Moretti, A.; Logrieco, A.F. Alternaria Species Associated to Wheat Black Point Identified through a Multilocus Sequence Approach. Int. J. Food Microbiol. 2019, 293, 34–43. [Google Scholar] [CrossRef] [PubMed]
- Tamura, K.; Stecher, G.; Kumar, S. MEGA11: Molecular Evolutionary Genetics Analysis Version 11. Mol. Biol. Evol. 2021, 38, 3022–3027. [Google Scholar] [CrossRef] [PubMed]
- Berkow, E.L.; Lockhart, S.R.; Ostrosky-Zeichner, L. Antifungal Susceptibility Testing: Current Approaches. Clin. Microbiol. Rev. 2020, 33, 1–30. [Google Scholar] [CrossRef]
- The State Handbook of Pesticides and Agrochemicals for 2024. Available online: https://lysterra.ru/poleznoe/spravochnik/ (accessed on 5 November 2024).
- Baiyee, B.; Ito, S.-I.; Sunpapao, A. Trichoderma asperellum T1 Mediated Antifungal Activity and Induced Defense Response against Leaf Spot Fungi in Lettuce (Lactuca sativa L.). Physiol. Mol. Plant Pathol. 2019, 106, 96–101. [Google Scholar] [CrossRef]

| Grapevine Varieties | Genotype | Incidence of Disease, % | Severity of the Disease, % | |
|---|---|---|---|---|
| Euro-American hybrids | Bianka | (V. vinifera + V. labrusca + V. riparia + V. rupestris + V. berlandieri + V. aestivalis + V. cinerea) × V. vinifera | 81.2 ± 17.1 | 58.9 ± 7.8 |
| Moldova | (V. vinifera × (V. vinifera + V. labrusca + V. riparia + V. rupestris + V. berlandieri + V. aestivalis + V. cinerea) | 30.4 ±11.4 | 22.4 ± 2.7 | |
| Avgustin | V. vinifera × (V. vinifera + V. labrusca + V. rupestris + V. berlandieri + V. lincecumii) | 38.0 ± 16.9 | 24.4 ± 4.1 | |
| Dunavski Lazur | V. vinifera × (V.vinifera + V. labrusca + V. rupestris + V. berlandieri + V. lincecumii.) | 43.8 ± 5.4 | 22.4 ± 3.0 | |
| Pervenets Magaracha | V. vinifera × (V. vinifera × (V. vinifera + V. riparia + V. rupestris)) | 55.2 ± 12.7 | 28.8 ± 5.1 | |
| Citronny Magaracha | V. vinifera +V. vinifera + V. labrusca | 15.1 ± 6.3 | 4.8 ± 1.8 | |
| Levokumskij | V. vinifera + V. labrusca | 89.9 ± 9.8 | 61.9 ± 4.8 | |
| Dekabrskii | V. vinifera × (V. vinifera + V. labrusca + V. rupestris + V. berlandieri + V. lincecumii) | 29.2 ± 3.7 | 14.7 ± 2.9 | |
| Doina | V. lincecumii +V. rupestris + V. vinifera | 34.2 ± 8.3 | 17.1 ± 4.4 | |
| Euro-Amur hybrids | Kunleany | (V. vinifera × V. amurensis) × V. vinifera convar. boreali-africana | 0 | 0 |
| Bruskam | V. vinifera × V. labrusca × V. amurensis | 0 | 0 | |
| Amur | V. vinifera convar. orientali-mediterranea × V.amurensis × V. vinifera | 0 | 0 | |
| Cristal | V. vinifera × V. amurensis | 5.1 ± 1.5 | 3.5 ± 0.9 | |
| Vostorg | V. vinifera × V. amurensis | 7.4 ± 4.1 | 3.1 ± 1.7 | |
| European varieties | Risling Rejnski | V. vinifera convar occidentalis subconvar. gallica | 14.3 ± 8.1 | 5.2 ± 1.8 |
| Sauvignon Blanc | 26.4 ± 6.1 | 9.0 ± 1.0 | ||
| Aligote | 11.2 ± 1.8 | 2.5 ± 0.7 | ||
| Chardonnay | 10.5 ± 1.2 | 0.8 ± 0.2 | ||
| Pinot blanc | 5.3 ± 0.9 | 2.0 ± 0.3 | ||
| Muller Thurgau | 29.1 ± 5.7 | 9.2 ± 1.2 | ||
| Traminer Pink | 0 | 0 | ||
| Cabernet Sauvignon | 0 | 0 | ||
| Merlo | 3.7 ± 0.6 | 0.7 ± 0.1 | ||
| Saperavi | V. vinifera convar pontica subconvar. georgica | 2.3 ± 0.2 | 0.9 ± 0.1 |
| Isolate | Grapevine Varieties | ||||
|---|---|---|---|---|---|
| Avgustin | Levokumskij | Bianka | Moldova | Pervenets Magaracha | |
| A-401-1 | + | + | + | + | + |
| A-402-1 | +++ | +++ | +++ | + | + |
| A421-2 | + | + | + | + | + |
| A-422-1 | ++ | ++ | ++ | - | - |
| A-422-2 | - | - | - | - | - |
| A-424-2 | ++ | ++ | ++ | ++ | - |
| A-426-2 | - | - | - | - | - |
| A-429-1 | + | + | + | + | - |
| A-429-2 | +++ | +++ | +++ | +++ | +++ |
| A-429-3 | + | + | + | + | + |
| A-443 | + | + | ++ | ++ | - |
| A-447 | + | + | + | - | - |
| A-448 | ++ | + | ++ | - | ++ |
| A-451 | ++ | + | + | + | ++ |
| A-452 | + | + | + | + | + |
| Gene Sequence | Total Sites | Constant Sites | Variable Sites | Parsimony-Informative Sites | Singleton Sites | Polymorphic Sites (%) |
|---|---|---|---|---|---|---|
| Alt a1 | 445 | 416 | 28 | 28 | 0 | 6.3 |
| gapdh | 516 | 515 | 1 | 1 | 0 | 0.2 |
| ITS | 513 | 506 | 0 | 0 | 0 | 0 |
| tef1 | 569 | 564 | 5 | 3 | 2 | 0.9 |
| tub | 954 | 942 | 12 | 9 | 3 | 1.3 |
| Gene Sequence | Total Sites | Constant Sites | Variable Sites | Parsimony-Informative Sites | Singleton Sites | Polymorphic Sites (%) |
|---|---|---|---|---|---|---|
| Alt a1 | 445 | 353 | 92 | 69 | 23 | 20.7 |
| gapdh | 506 | 464 | 42 | 29 | 13 | 8.3 |
| ITS | 479 | 470 | 5 | 3 | 2 | 1.0 |
| Index | Strains of Trichoderma sp. | ||||||||||||||
|---|---|---|---|---|---|---|---|---|---|---|---|---|---|---|---|
| Tk-1 | T1 | T1 | T3 | T4 | T5 | T-213 | T338 | T-404/1 | T-441/1 | T-503 | F-218 | F-219 | F-294 | F-838 | |
| PIRG *, % | 54.6 | 52.7 | 61.8 | 58.3 | 70.6 | 59.7 | 86.0 | 87.4 | 91.3 | 79.5 | 82.8 | 34.9 | 59.8 | 71.7 | 92.1 |
Disclaimer/Publisher’s Note: The statements, opinions and data contained in all publications are solely those of the individual author(s) and contributor(s) and not of MDPI and/or the editor(s). MDPI and/or the editor(s) disclaim responsibility for any injury to people or property resulting from any ideas, methods, instructions or products referred to in the content. |
© 2024 by the authors. Licensee MDPI, Basel, Switzerland. This article is an open access article distributed under the terms and conditions of the Creative Commons Attribution (CC BY) license (https://creativecommons.org/licenses/by/4.0/).
Share and Cite
Yurchenko, E.; Karpova, D.; Burovinskaya, M.; Vinogradova, S. Leaf Spot Caused by Alternaria spp. Is a New Disease of Grapevine. Plants 2024, 13, 3335. https://doi.org/10.3390/plants13233335
Yurchenko E, Karpova D, Burovinskaya M, Vinogradova S. Leaf Spot Caused by Alternaria spp. Is a New Disease of Grapevine. Plants. 2024; 13(23):3335. https://doi.org/10.3390/plants13233335
Chicago/Turabian StyleYurchenko, Evgeniya, Daria Karpova, Margarita Burovinskaya, and Svetlana Vinogradova. 2024. "Leaf Spot Caused by Alternaria spp. Is a New Disease of Grapevine" Plants 13, no. 23: 3335. https://doi.org/10.3390/plants13233335
APA StyleYurchenko, E., Karpova, D., Burovinskaya, M., & Vinogradova, S. (2024). Leaf Spot Caused by Alternaria spp. Is a New Disease of Grapevine. Plants, 13(23), 3335. https://doi.org/10.3390/plants13233335

